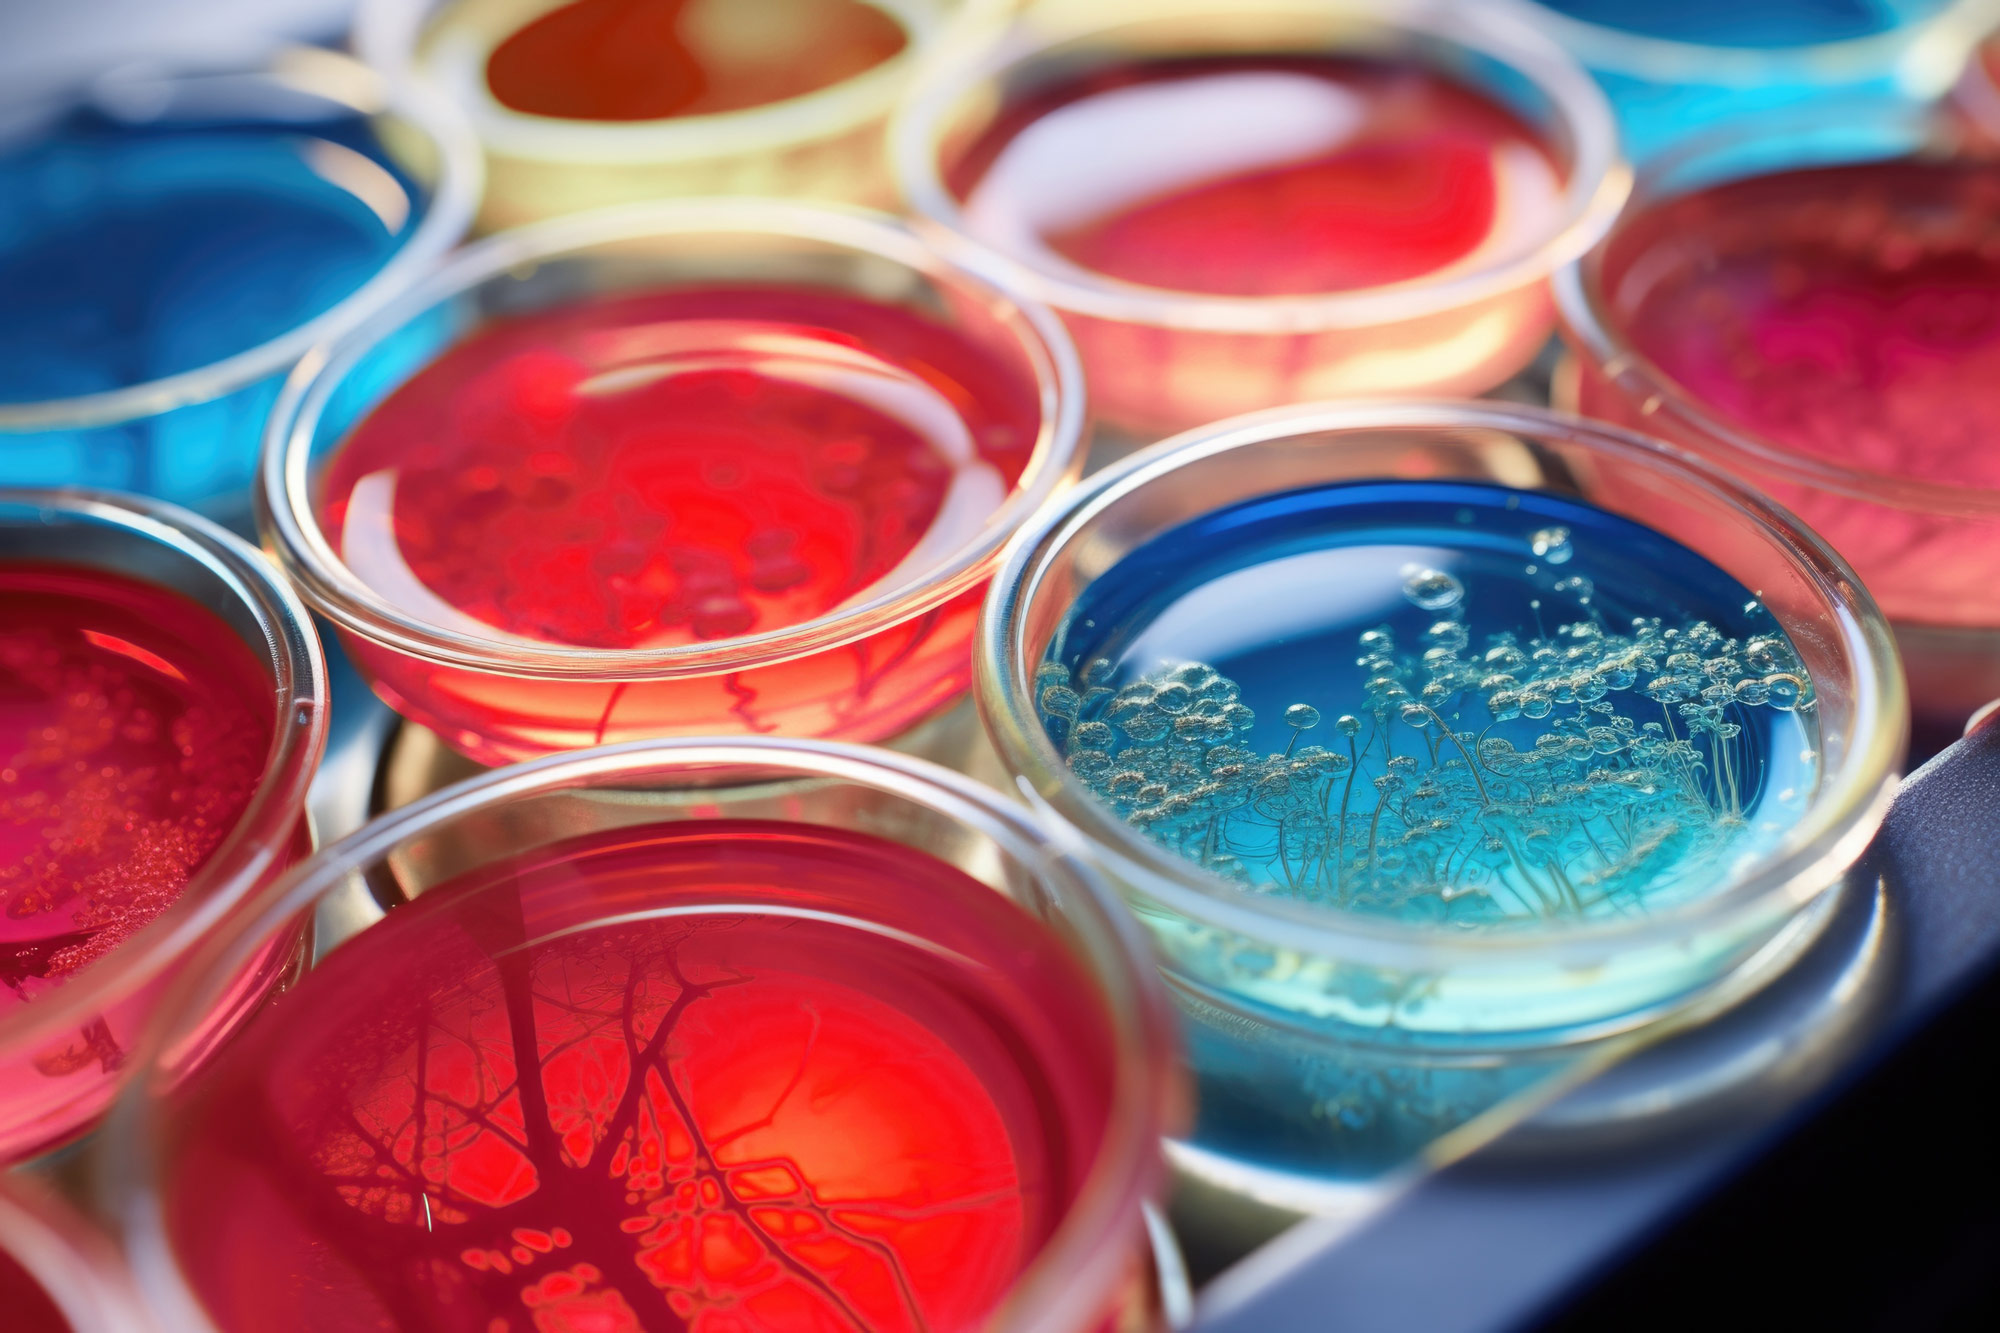
biotech Agency Consulting firm Experts Specialists Consultancy

Biotech Consulting
30 years of experience supporting decision-makers in the biotech sector
Our specialized team has been supporting everyday biotech players in their innovation and new market development projects: new technologies and therapeutic approaches, R&D and commercial strategies, understanding the patient journey, market access, regulatory changes, …
Biotech players trust us










How we support our partners in the biotech sector
Founded in 1993, Alcimed is a consulting firm specialized in innovation and new business. Spread over our 8 offices in the world (in the USA, Europe, and Singapore), our team of 220 high-level consultants supports everyday corporate management and operational decision-makers (heads of marketing, R&D, innovation, strategy, CSR, industrial operations, etc.) in their innovation and new business projects.
Our projects for biotech players cover topics as diverse as new technologies and therapeutic approaches, R&D and commercial strategies, understanding disease management and care pathways, assessing market and licensing opportunities, drawing up business plans and roadmaps, market access, regulatory changes, partner search, and much more!
And our activities are not limited to the biotech sector. The diversity of our clients (manufacturers, ETIs, innovative start-ups, institutions, etc.), the subjects we deal with, and the geographical areas we explore, enable us to master a wide range of missions and develop recognized expertise in our specialized sectors.
Our missions
Our expertise
Our missions
Strategic marketing
Clients & Patients
R&D
Commercial strategy
Innovation
New partners
Our expertise
Healthcare
Environment & Climate
Beauty & Nutrition
Energy & mobility
Sovereignty
What our clients say
-


"The benefit that really Alcimed brought to the table was to have an expert intermediary to take us through the process to really challenge our thinking."
Mark TWYMAN
Senior VP and Chief Commercial Officer
-

"A friendly and efficient team!"
"We recently worked with Alcimed to support us in one of our projects. A project well carried out, with a friendly and efficient team, which respects the timings!"
Jean-Baptiste CAQUELIN
Marketing Director France
-

"Alcimed played a decisive role in the selection of the CIL'LICO consortium project."
"By bringing together multiple interests, streamlining the pace of effort for each stakeholder, and coordinating different viewpoints, Alcimed played a decisive role in the selection of the CIL'LICO consortium project, winner of the RHU (University Hospital Research Program) wave 3 competition."
Jean-Philippe ANNEREAU
CEO and Co-Founder
Our case studies in the biotech sector
-
State of the art of technologies and players in the field of oligonucleotides for a biotech company
We supported a biotech company in the realization of a state of the art in the field of oligonucleotides (oligonucleotides consist of short segments of nucleic acids: RNA or DNA). In a context of growth and consequently of evolution of its R&D activities, our client wanted to acquire oligonucleotides technologies or to establish a partnership with an expert company in the field.
Having a limited vision of this complex domain at a global level, our client called our team to carry out a state of the art aiming at identifying and characterizing existing technologies and players worldwide, in order to select a panel of technologies and associated players of interest for our client. In the end, our project enabled our client to start discussions with 3 key selected players and to decide on an important investment for the future of its Research & Development activities.
-
Characterizing and sizing mRNA therapy market potential
Alcimed worked with a major biotech player to understand the potential market opportunity of a new mRNA therapeutic in the cardiology space.
Alcimed analyzed the full picture of the targeted cardiac disease, detailing the epidemiology, economic burden, current standard of care, unmet therapeutic needs, and an understanding from key opinion leaders why so many potential therapeutics have already failed to show efficacy in the space. Based on this analysis, Alcimed was able to model what the potential peak sales would be for the new mRNA therapeutic based on how they would likely fare against the current and potential future competitor therapies in the space.
Our client was able to leverage Alcimed’s analysis to make crucial go/no go decisions on the R&D pipeline project, eventually leading to green lighting the program and landing a crucial development partnership with a major pharma player.
-
Project roadmap for the launch of an orphan drug in Europe
Alcimed assisted an American biopharmaceutical client in defining the launch strategy of its orphan drug in Europe, and then in structuring a concrete and operational plan, both at the level of the European region and at the level of each targeted country.
The launch plan is a roadmap for each of the company’s key functions (medical, marketing, production, regulatory, sales) and covers the period from pre-launch (before obtaining the MA – Marketing Authorization) to the first sales.
Today, our team is still involved in regularly updating the first plan defined with our client, according to internal or external developments around this orphan drug in several European countries.
-
Selection of the best development opportunities for a gene therapy in rare diseases
We supported a biotech company specialized in gene therapy for rare diseases in one of its strategic development projects. Our client’s goal was to build a franchise in the field of neuro-ophthalmology for the next 5 years.
The main challenge being related to the nature of rare diseases (little or no information, a strong dispersion of patients, poorly optimized care pathways, strong disparities between geographies…), we assisted our client in a commercial pre-evaluation on 3 rare ophthalmic diseases: description of the disease, epidemiological analysis, diagnosis and treatment practices, competitive landscape, unmet needs,… in order to guide our client towards commercial opportunities, indicate how to address them, and recommend the opportunity to work on in priority.
-
Construction of a portfolio strategy in gene therapy
One of our clients, a major player in gene therapy, wanted to understand how to change its portfolio strategy by engaging in new therapeutic areas.
To this end, Alcimed carried out 7 opportunity assessments for different diseases by identifying their potential (disease severity, impact on the healthcare system, opportunity for gene therapy, patient population, etc.) and the associated risk (current treatments, risks for gene therapy linked to the healthcare structure already in place, feasibility of a clinical trial, etc.).
With the business cases built, the new therapeutic areas considered were compared and prioritized, the synergies evaluated, in order to orient our client’s developments in a portfolio logic.
-
Search for public and semi-public funding opportunities for the creation of a translational R&D center for mRNA
A leading pharmaceutical client had launched a medical center of excellence in mRNA in 2021 that was dedicated to vaccines, with the objective of accelerating the development and delivery of next-generation vaccines. Our client wanted to maintain this dynamic by opening a medical center of development for mRNA technologies dedicated to preclinical, clinical, and translational research activities.
Our team initially identified public and semi-public financing opportunities for this project, then characterized them (concerned domains, eligibility criteria, funding amount, etc.) and selected the best opportunities by taking into account the needs and specific context of the client. Finally, Alcimed equally supported the client in developing their roadmap in this new R&D center.
-
Support for a biotech in identifying the best indications and sub-populations for developing and positioning its new immunotherapy
Our customer, a biotech, wanted to identify the main solid tumor indication among four (breast, prostate, lung and colorectal cancer) and the main associated sub-populations to develop and position its new immunotherapy.
We first identified the sub-populations in each indication, their treatments and the potential of immunotherapy through a literature review and interviews with industry experts. Our teams then assessed physicians’ receptiveness to the solution and identified its most relevant entry point, then characterized its potential place in the treatment plan and the size of the corresponding population.
In this way, we were able to identify different patient profiles and development opportunities for our customers, each with their own risks and potential benefits, to position their new immunotherapy.
-
Landscaping of gene editing and delivery technologies for a biotech player
Alcimed supported a biotech company in understanding the current technological landscape of gene editing and transgene delivery technologies.
To support them, our team performed a global analysis of tools for optimizing gene therapy by conducting a thorough technological and IP assessment in this field. The analyzed technologies included gene editing optimization, AAV optimization, expression regulation technologies, non-viral vectors, transgene optimization, and other tools. We then assessed the importance of these technologies based on their individual maturity levels and their compatibility with our client’s key selection criteria.
Through this study, our client was able to gain an in-depth understanding of the state of the art of gene editing tools and a high priority list of technologies to pursue to develop their business portfolio.
-
Receptivity study of a synthetic biology technology for microorganism development in the healthcare, cosmetics, food, and feed sectors
We supported our client, a company in the biotech industry specialized in gene engineering on micro-organisms, in better understanding the potential for microorganism development in the healthcare, cosmetics, food, and feed sectors.
Our team help our client in defining and prioritizing its market by performing interviews with key opinion leaders and representatives of industrial players located in the sectors of interest.
The key expected features were derived in a consistent value proposition, and subsequently a refined business model on the sector with the highest interest was developed.
Have a project and want to discuss it?
Our insights on the biotech sector
-
Healthcare
Molecular pharming: how plant-based pharmaceuticals can revolutionize drug development and manufacturing?
What are the benefits of molecular pharming? Why can plant-based pharmaceuticals be interesting pharmaceutical alternatives? Alcimed explored the potential of molecular pharming to revolutionize drug ...
-
Healthcare
Long-read sequencing: mechanisms, promises and applications in Healthcare
How do the 2 main technologies on the market work? What are the promising applications in the study of cancers and viral genomes?
-
Cross-sector
The Belgian biotech scene: 3 reasons why Belgium is a biotech powerhouse
Belgian biotech companies account for 16% of Europe’s biotech turnover. What are the three major building blocks of this Belgian success story?
Founded in 1993, Alcimed is an innovation and new business consulting firm, specializing in innovation driven sectors: life sciences (healthcare, biotech, agrifood), energy, environment, mobility, chemicals, materials, cosmetics, aeronautics, space and defence.
Our purpose? Helping both private and public decision-makers explore and develop their uncharted territories: new technologies, new offers, new geographies, possible futures, and new ways to innovate.
Located across eight offices around the world (in the USA, Europe, and Singapore), our team is made up of 220 highly-qualified, multicultural and passionate explorers, with a blended science/technology and business culture.
Our dream? To build a team of 1,000 explorers, to design tomorrow’s world hand in hand with our clients.
Alcimed carries out consulting missions in a variety of fields and on topics as diverse as the uncharted territories of our clients! Our projects and the methodological approaches we develop are based on the specific needs and contexts of our clients. We for example support our clients in defining their R&D or innovation strategy, in studying their target markets, in identifying and exploring new opportunities, in investigating innovative technologies, in defining their sales and marketing strategies, in integrating CSR or data science into their practices, or in imagining the future of their activities.
We have chosen to operate without using pre-established methodologies. Our consultants always start from the context and from the specific questions of our clients and think about the best way to provide clear answers. Let’s forget methodological approaches of copy-pasting.
We’re not consultants, we’re explorers! Working with a consulting firm like Alcimed means living a different experience, with a team that always favors face-to-face meetings, goes beyond classic deliverables in favor of innovative ones (videos, data visualization tools, websites, collaborative platforms, …), that favors interactive animations in projects (escape games, quizzes, board games, role-playing games, video games, …), and that loves to make clients discover unusual places!
Beyond analyzing the web and literature, and large internal or external data lakes using data science, our consultants target and interact with key stakeholders: these can be clients, suppliers, partners, experts, opinion leaders, end-customers or patients, … and we challenge their viewpoints. This investigative work enables us to build our clear opinion at the crossroads between the viewpoints of the different stakeholders, and leads us to build recommendations to allow our clients to make decisions.
Our team consists of 220 passionate individuals, with degrees from the best international schools and universities , most possessing a dual education in science/technology and business or data science. More than a third of our consultants have an international and multicultural background, and we master more than 20 languages and cultures, including the world’s most widely spoken ones: English, Chinese, French, Spanish, Portuguese, Russian, Arabic and Japanese.


